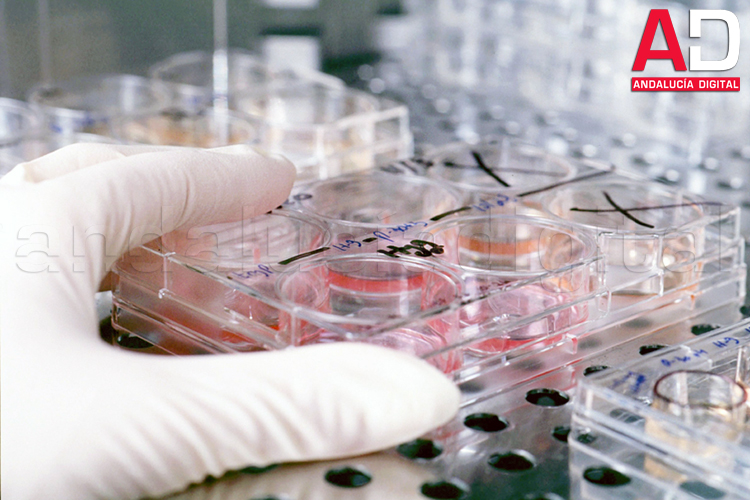

El Servicio de Teleasistencia de la Junta de Andalucía, que gestiona la Consejería de Igualdad, Políticas Sociales y Conciliación, atendió 318.852 llamadas en la provincia de Córdoba en el primer semestre del año, lo que supuso una media de 1.752 llamadas gestionadas al día. Este servicio…
El Ayuntamiento de Santaella confirma el primer caso positivo por covid-19 desde el final del confinamiento
El Ayuntamiento de Santaella confirmó anoche, por medio de un comunicado en redes sociales, el primer caso positivo por covid-19 desde el final del confinamiento. Por ello, desde el Consistorio se pidió a toda la población que "se extremen las medidas de distanciamiento", así co…
El escritor y periodista Antonio López Hidalgo publica un libro de relatos titulado 'Maneras de soñar y de vivir'
El escritor y catedrático de Periodismo Antonio López Hidalgo, miembro del Consejo Editorial de Andalucía Digital , publica Maneras de soñar y de vivir , un libro que contiene 80 relatos breves escritos en su mayor parte en Lima (Perú) y en Quito (Ecuador), donde muestra una mirada existe…
Las autoridades confirman 23 nuevos casos positivos por coronavirus en Montalbán y siete en La Rambla
El coronavirus sigue mostrando una elevada incidencia en la Campiña Sur cordobesa, a tenor de los últimos datos facilitados esta tarde por dos municipios vecinos. Y es que, mientras el Ayuntamiento de Montalbán ha notificado 23 nuevos casos positivos por covid-19 en las últimas 24 horas, …
Mediodía. La chicharra se desgañita anunciando otro día de cielo y sol blancos. Poco ha permanecido la pobre callada, solo cuatro horas ha podido mi casa respirar aire de fuera –decir "libre" sería mentir–. Mi cerebro calcula las horas para volver a la cama como si deseara que &…
La Consejería de Salud contabiliza 47 nuevos positivos por covid-19 en la provincia en las últimas 24 horas
La Consejería de Salud y Familias de la Junta de Andalucía acaba de confirmar 47 nuevos casos positivos por coronavirus en la provincia de Córdoba en las últimas 24 horas. De este modo, el número total de afectados en toda la provincia asciende a 1.871, de los que 581 han estado ingresado…
La Delegación de Igualdad de la Diputación abre el plazo de inscripción a una nueva acción formativa
La Delegación de Igualdad de la Diputación de Córdoba ha abierto el plazo de inscripción para participar en un curso de formación que será impartido de manera telemática entre el 21 de septiembre y el 16 de noviembre próximos y en el que podrán participar hasta 170 personas. Para la re…